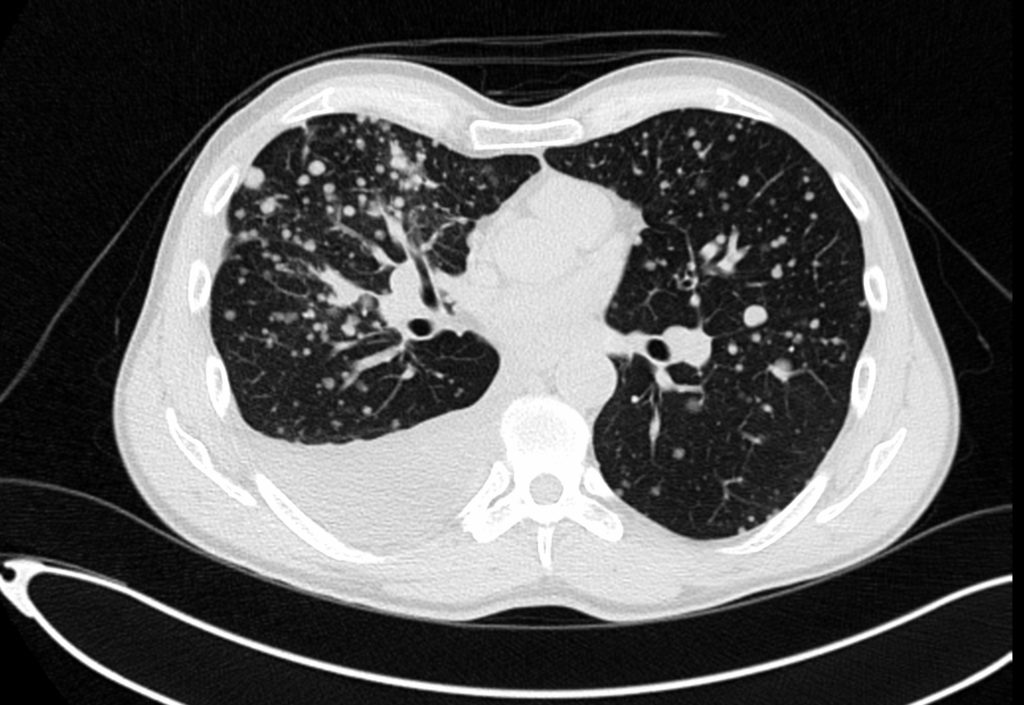

CT torace
Tomografia computerizată a toracelui determină posibile afecţiuni ale plămânilor, inimii, esofagului şi ale principalelor vase sanguine.
Afecţiunile ce pot fi descoperite la scanare sunt:
- modificări ale ţesutului pulmonar (enfizem, fibroză), infecţii, tumori, embolii ale vaselor pulmonare sau anevrisme;
- gradul de metastazare a cancerului la nivelul toracelui;
- volumetria formaţiunilor tumorale și a adenopatiilor la nivelul mediastinului și al parenchimului pulmonar;
- starea vaselor mari din mediastin, prezența maselor ganglionare, aspectul esofagului;
- angiografia aortei toracale detectează anevrisme, disecţii, coarctație;
- angiografia pulmonară detectează emboliile pulmonare, în timp ce angiografia coronariană evidenţiază starea arterelor coronare. Această investigaţie este neinvazivă, tinzând să înlocuiască angiografia prin cateterizare.